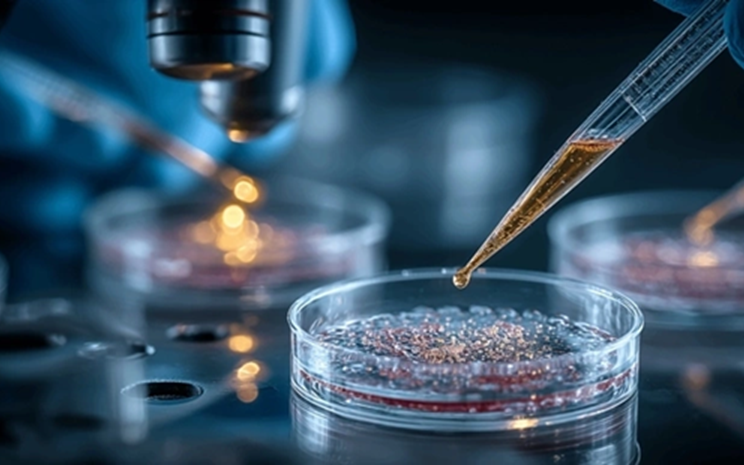
Tế b&agrave;o da phụ nữ c&oacute; thể sản xuất tinh tr&ugrave;ng? C&aacute;c nh&agrave; khoa học Nhật Bản: Sớm nhất 7 năm nữa th&agrave;nh hiện thực

Thực hư chuyện tắm nước nóng có thể làm giảm chất lượng "tinh binh"
Có nhiều lời đồn đại rằng tắm nước nóng có thể làm suy giảm chất lượng "tinh binh" ở nam giới, từ đó làm tăng nguy cơ vô sinh. Hãy cùng xem khoa học nói gì.
Nhiệt độ cao và những tác động lên “tinh binh”
Theo tờ Times of India, nhiệt độ vùng tinh hoàn là yếu tố then chốt quyết định khả năng sinh sản của nam giới. Tinh hoàn nằm bên ngoài cơ thể để luôn duy trì mức nhiệt thấp hơn khoảng 4°C so với thân nhiệt. Đây là mức nhiệt lý tưởng để tinh trùng được sản xuất khỏe mạnh và ổn định.
Tuy nhiên, khi tắm nước quá nóng và tắm trong thời gian quá lâu, mức nhiệt này dễ dàng bị phá vỡ. Theo Harvard Health Publishing, chỉ cần tăng thêm từ 2 - 4 độ C, như khi nam giới ngâm mình quá lâu trong nước nóng, chất lượng tinh trùng đã có thể bị ảnh hưởng.

Tắm nước quá nóng có thể ảnh hưởng tới chất lượng "tinh binh" (Ảnh minh họa).
Khi tinh hoàn bị làm nóng quá mức, hai hậu quả thường gặp nhất là:
Suy giảm số lượng và khả năng di chuyển của tinh trùng: Nhiệt độ cao khiến tinh trùng yếu đi, giảm vận động và dễ chết trước khi kịp di chuyển đến trứng. Tổn thương DNA tinh trùng: Tinh trùng có thể bị biến dạng về hình thái, kích thước lẫn chức năng, làm giảm khả năng thụ tinh.
Không chỉ ảnh hưởng đến tinh trùng, việc tắm nước quá nóng và quá lâu còn có thể tác động đến testosterone - hormone đóng vai trò quan trọng đối với sức khỏe sinh sản và sinh lý nam giới. Sự suy giảm testosterone kéo theo mệt mỏi, giảm ham muốn và giảm chất lượng "tinh binh".
Ngoài thói quen tắm nước quá nóng, các chuyên gia cũng lưu ý rằng những yếu tố khác cũng có thể làm tăng nhiệt vùng kín như mặc quần quá chật, ngồi với laptop trên đùi hoặc làm việc trong môi trường nóng bức. Việc duy trì những thói quen này trong thời gian dài có thể khiến chất lượng “tinh binh” bị suy giảm.
Giữ nhiệt độ ổn định để bảo vệ “tinh binh”
Tiến sĩ Parul Gupta Khanna, một chuyên gia về IVF (thụ tinh ống nghiệm) và điều trị vô sinh hiếm muộn nổi tiếng tại New Delhi (Ấn Độ), cho biết tinh trùng rất nhạy cảm với sự thay đổi nhiệt độ. Khi tiếp xúc thường xuyên với môi trường quá nóng, như phòng xông hơi hoặc bồn tắm nước nóng, tinh trùng chịu tác động trực tiếp, dẫn đến:
Suy giảm chức năng ty thể trong tinh trùng (ty thể là nguồn năng lượng giúp tinh trùng bơi và tiếp cận trứng). Tổn thương DNA tinh trùng, làm biến dạng vật liệu di truyền và làm tăng nguy cơ bất thường về hình thái, chất lượng.
Theo vị chuyên gia này, nam giới đang trong quá trình chuẩn bị có con nên hạn chế tối đa ngâm bồn nước nóng, không ở phòng xông hơi quá lâu, đồng thời ưu tiên mặc trang phục thoáng khí và tránh môi trường gây nóng vùng hạ vị.
Làm thế nào để duy trì chất lượng “tinh binh”?
Để giữ tinh trùng luôn khỏe mạnh, nam giới có thể áp dụng những thói quen đơn giản nhưng hiệu quả sau:
Ngủ đủ giấc: Giấc ngủ tốt giúp ổn định hormone và tăng cường sinh sản.
Khám sức khỏe định kỳ: Giúp phát hiện sớm các vấn đề ảnh hưởng đến khả năng thụ thai.
Tránh rượu bia, thuốc lá và chất kích thích: Đây là những yếu tố làm giảm mạnh số lượng lẫn chất lượng tinh trùng.
Hạn chế dùng thiết bị điện tử buổi tối: Ánh sáng xanh ức chế melatonin - hormone giúp bảo vệ tinh trùng khỏi stress nhiệt.
Duy trì lối sống lành mạnh: Ăn uống điều độ, tập luyện đều đặn và kiểm soát tốt các bệnh nền như tiểu đường hoặc tăng huyết áp.